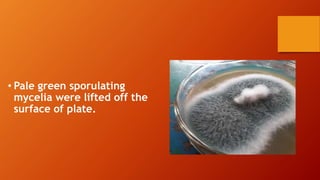
• Pale green sporulating
mycelia were lifted off the
surface of plate.

The document outlines the production technology for bioagents, specifically focusing on the preparation of potato dextrose agar culture medium and the isolation of Trichoderma species using serial dilution methods. It includes detailed procedures for sterilization, cultivation, and the scientific classification of Trichoderma. Additionally, it describes methods for the application of Trichoderma as a bioagent in various agricultural treatments.

![•7 days old culture of Trichoderma grown on potato dextrose agar
medium was used for inoculation.
•Five mycelial discs [5mm] of above culture was inoculated in each
bag and incubated after15 days at room temperature (27± 2⁰C)
four replications were kept for each treatment.
•After 15 days of inoculation, the sub-strate were hurried thoroughly
polypropylene bags. 1 gram of sample from each substrate was
drawn aseptically for colony counts.](https://image.slidesharecdn.com/productiontechnologyforbioagentsandbiofertilizers-200430045007/85/Production-technology-for-bioagents-and-biofertilizers-2-18-320.jpg)


